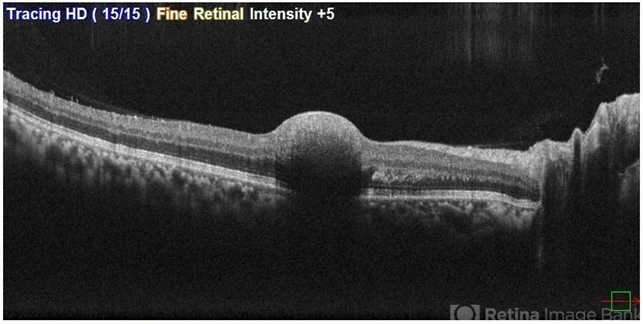
file

-
 By Malvika Singh
By Malvika Singh
Retina Foundation
Co-author(s): Dr Manish Nagpal, Retina Foundation, Ahmedabad, India - Uploaded on Apr 17, 2025.
- Last modified by Joshua Friedman on Apr 17, 2025.
- Rating
- Appears in
- Miscellaneous
- Condition/keywords
- SUB ILM hemorrhage, optical coherence tomography (OCT)
- Photographer
- Dr Malvika Singh, Retina Foundation, Ahmedabad, India
- Imaging device
-
Optical coherence tomography system
Mirante SLO/OCT - Description
- OCT of a 41 year-old, male, with a central retinal vein occlusion and a foveal sub-internal limiting membrane hemorrhage.

Initializing download.
Initializing download.










